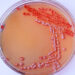
Įprastinis skreplių pasėlis

Skiriant daug dėmesio ankstyvam išsėtinės sklerozės (IS) gydymui, galima pristabdyti ligos eigą ir sumažinti sunkių simptomų ar neįgalumo riziką ateityje. Kuo anksčiau aptarsite tinkamą gydymo planą su gydytoju, tuo daugiau galimybių išvengti ilgalaikių pasekmių.
Kodėl gydymą svarbu pradėti kuo anksčiau
Ne vienam žmogui sprendimas, kada pradėti IS gydymą, nėra paprastas. Dažnai, jei simptomai dar neryškūs, o vaistai gali sukelti šalutinį poveikį, norisi atidėti gydymą. Vis dėlto svarbu žinoti, kad IS yra visą gyvenimą trunkanti liga, ir anksti taikomos priemonės gali stabdyti symptomų blogėjimą.
Kaip IS pažeidžia nervų sistemą
Nervinių impulsų perdavimas organizme priklauso nuo nervų skaidulų ir jas saugančio mielino sluoksnio. Sergant IS, imuninė sistema atakuoja šį sluoksnį, todėl nervai tampa pažeidžiami. Dėl to gali susidaryti randai galvos ar nugaros smegenyse, regos nerve. Laikui bėgant, ryšys tarp smegenų ir kūno silpsta – tai sukelia vis daugiau neurologinių sutrikimų.
Ligos eiga ir atsinaujinimai
Apie 85 procentus žmonių su IS nustatoma recidyvuojanti-remituojanti forma (RRIS). Jos metu ligos paūmėjimai (recidyvai) keičiasi palengvėjimo laikotarpiais (remisija). Ligos progresas dažnai susijęs su kiekvieno paūmėjimo metu patiriama papildoma nervų žala.
Kaip ligos eigą veikia gydymas
Ligos eigą lėtinantys vaistai (DMT) ypač svarbūs ankstyvame IS etape. Jie veikia imuninę sistemą, padeda sumažinti atkryčių gausą ir sunkumą bei saugo nuo ilgalaikės neurologinės žalos. Pradėjus gydymą iškart po pirmo IS epizodo, mažėja rizika patirti vidutinį ar ryškų neįgalumą vėlesniais metais.
- Tyrimai rodo, kad žmonės, pradėję DMT per pusę metų nuo pirmųjų IS požymių, net 45 proc. rečiau susiduria su vėlesniu vidutiniu neįgalumu, palyginus su tais, kurie pradėjo po 16 mėnesių.
- Rizika pereiti į antrinę progresuojančią IS formą (SPIS) taip pat sumažėja net 60 procentų, jei gydymas taikomas anksti.
Progresuojanti IS forma: ar vėlyvas gydymas padeda?
RRIS, laikui bėgant, gali tapti SPIS, kuomet išnyksta remisijos periodai ir simptomai nuolat blogėja. Anksčiau manyta, kad DMT nebepadeda aktyviai SPIS, tačiau pastaruoju metu vis daugiau tyrimų rodo – net ir pradėjus gydymą vėliau, galima gauti naudos, jei SPIS forma išlieka aktyvi.
Neapdorotas IS: kai pasekmės tampa rimtos
Jei IS negydoma, po 20–25 metų net 80–90 procentų sergančiųjų patiria stiprų neįgalumą. Kadangi diagnozė dažniausiai nustatoma nuo 20 iki 50 metų, kyla rizika ilgam prarasti savarankiškumą darbo ar kasdieniame gyvenime. Kuo anksčiau pradedate gydymą, tuo geresnės Jūsų galimybės išvengti sunkių ligos komplikacijų. Deja, vaistai negali atkurti jau prarastos nervų sistemos funkcijos – būtent todėl ankstyva intervencija yra itin svarbi.
Rizikų ir privalumų aptarimas
Nors DMT gali būti labai veiksmingi, jie taip pat turi galimų šalutinių poveikių – nuo lengvų peršalimo simptomų ar odos sudirgimų iki retesnių, bet sunkesnių komplikacijų. Svarbu iš anksto aptarti tiek naudas, tiek rizikas su savo gydytoju ir kartu pasirinkti tinkamiausią kelią.
Ko galima tikėtis taikant gydymą
Ankstyvasis gydymas IS dažniausiai leidžia pristabdyti nervų sistemos uždegimą, sumažinti pažeidimus ir taip sulėtinti ligos progresą. Kartu taikomos priemonės simptomams kontroliuoti gali padėti sumažinti skausmą, pagerinti kasdienę savijautą bei išlaikyti aktyvų gyvenimo būdą.
Aptarkite gydymo galimybes
Kiekvieno žmogaus ligos eiga ir poreikiai yra individualūs, todėl svarbu atvirai kalbėtis su gydytoju apie ankstyvo gydymo naudą, rizikas ir prognozę. Bendras sprendimas gali užtikrinti maksimalų veiksmingumą tiek trumpuoju, tiek ilguoju laikotarpiu.